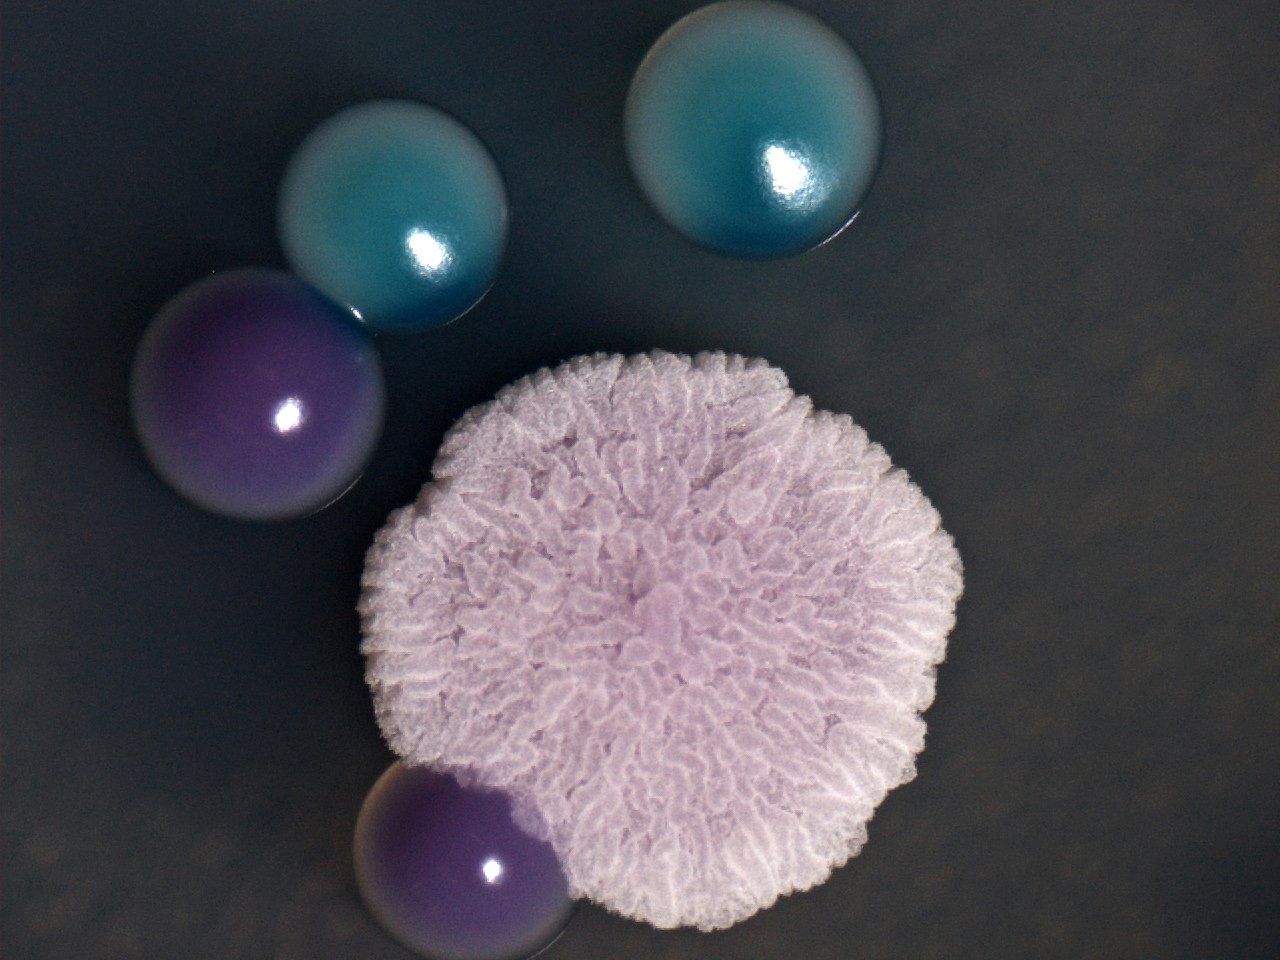

Sergio Seoaneren “Todos los días sale el sol” izeneko argazkiak irabazi du Biomedikuntza arloko Mikroargazkigintzako III. Lehiaketa. EHUko Landareen Biologia eta Ekologia saileko ikerlaria da Seoane doktorea. Epaimahaiak irudiaren indarra, zailtasun teknikoa eta erakutsitako emaitzaren garrantzia azpimarratu ditu. Ekortze-mikroskopia elektroniko bitartez hartutako Emiliania huxleyi itsas-alga zelulabakarraen irudia da. Organismo hauek oso garrantzitsuak dira itsas ekosistemarentzat, gure itsasoen kate trofikoaren oinarriaren parte direlako. Azaleko morfologia berezi horri esker identifika daitezke espezie desberdinak.
Bigarren saria, Cristina Marcos Arias EHUko Immunologia, Mikrobiologia eta Parasitologia saileko ikerlariarentzat izan da, “La huella de Cándida” argazkiagatik. Mikroskopia estereoskopikoz hartutako irudi honetan Candida generoko legamia espezie desberdinak ikus daitezke, kolore eta itxura desberdinarekin.
Eta hirugarren saria Asier Ruiz EHUko Neurozientziak saileko doktorearentzat izan da, “El abrazo” izeneko argazkiagatik. Mikroskopia fokukidez lortutako irudi honetan arratoien garun-azaleko hiru neurona ikusten dira
Lehiaketa hau EHUren Ikerkuntzarako Zerbitzu Nagusiaren (SGIker) baitan dagoen Biomedikuntzako Mikroskopia Analitikoa eta Bereizmen Handikoaren zerbitzuak antolatzen du, Biomedikuntzan mikroskopia optikoaren eta elektronikoaren arloan EHUn lortutako emaitzak hedatzeko asmoz. Lehiaketara aurkeztutako argazki guztiak hemen ikus daitezke: http://www.ehu.es/SGIker/fotos/


mikroargazkigintzako-iii-lehiaketa-1_239.358704234
-
mikroargazkigintzako-iii-lehiaketa-2_771.295515942
-

mikroargazkigintzako-iii-lehiaketa-3_454.072005404
-

Eklipseak miran
Astronomia

Sahara: bizikideak
Biodibertsitatea

Mexiko: koloreak hegan
Biodibertsitatea



